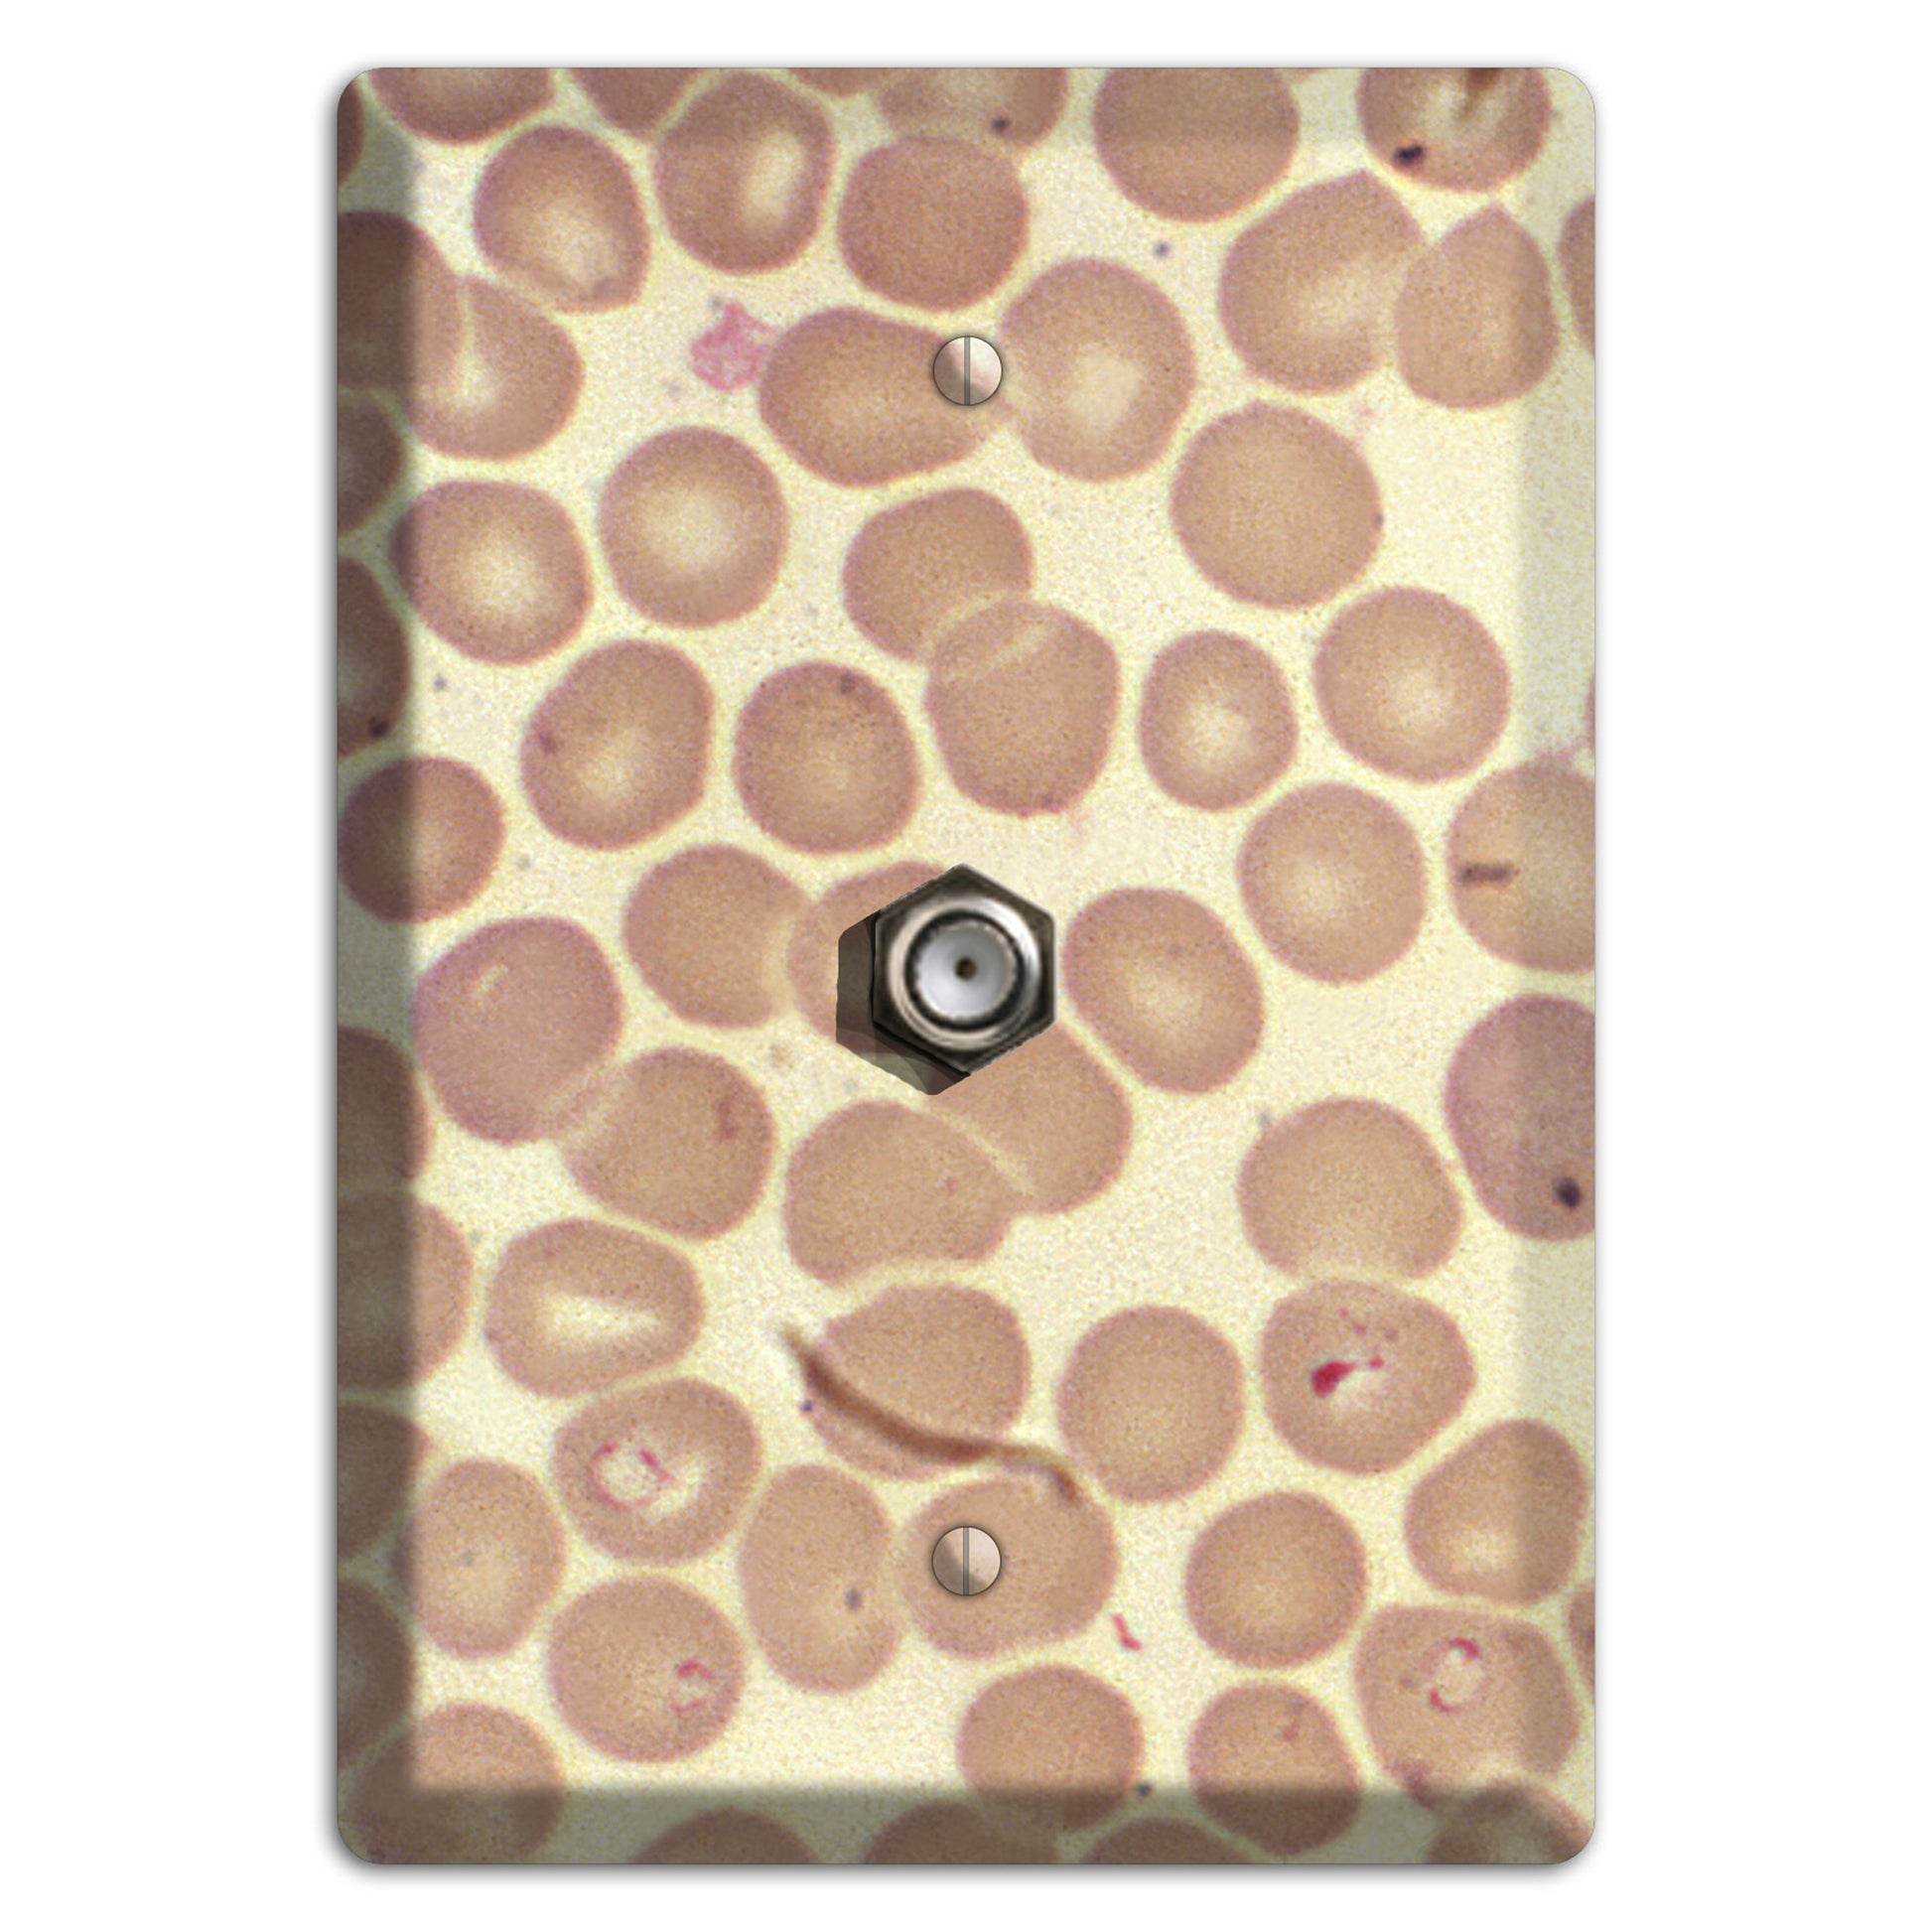
Babiesa Cable Wallplate

Cable
-

Streptococcus Mutans Cable Wallplate
Starting at:15.9913.99Streptococcus Mutans Cable Wallplate
Starting at: 13.9915.99 -

SMC Polyhydroxy Cable Wallplate
Starting at:15.9913.99SMC Polyhydroxy Cable Wallplate
Starting at: 13.9915.99 -

Plasmodium Falciparum Cable Wallplate
Starting at:15.9913.99Plasmodium Falciparum Cable Wallplate
Starting at: 13.9915.99 -

Perianal Gland Tumor Cytology Cable Wallplate
Starting at:15.9913.99Perianal Gland Tumor Cytology Cable Wallplate
Starting at: 13.9915.99 -

Mycobacterium Bovis Cable Wallplate
Starting at:15.9913.99Mycobacterium Bovis Cable Wallplate
Starting at: 13.9915.99 -

Morbillo Cable Wallplate
Starting at:15.9913.99Morbillo Cable Wallplate
Starting at: 13.9915.99 -

Measles Pneumonia Cable Wallplate
Starting at:15.9913.99Measles Pneumonia Cable Wallplate
Starting at: 13.9915.99 -

Plasmodium Malariae Schizont Cable Wallplate
Starting at:15.9913.99Plasmodium Malariae Schizont Cable Wallplate
Starting at: 13.9915.99 -

Mast Cell Tumor Cable Wallplate
Starting at:15.9913.99Mast Cell Tumor Cable Wallplate
Starting at: 13.9915.99 -

Marburg Cable Wallplate
Starting at:15.9913.99Marburg Cable Wallplate
Starting at: 13.9915.99 -

Macrophage Cable Wallplate
Starting at:15.9913.99Macrophage Cable Wallplate
Starting at: 13.9915.99 -

Gonococcal Urethritis Cable Wallplate
Starting at:15.9913.99Gonococcal Urethritis Cable Wallplate
Starting at: 13.9915.99 -

Esophagus Herpes Cable Wallplate
Starting at:15.9913.99Esophagus Herpes Cable Wallplate
Starting at: 13.9915.99 -

Entercoccus Cable Wallplate
Starting at:15.9913.99Entercoccus Cable Wallplate
Starting at: 13.9915.99 -

influenza A H5N1 Cable Wallplate
Starting at:15.9913.99influenza A H5N1 Cable Wallplate
Starting at: 13.9915.99 -

Bacillus Coagulans Cable Wallplate
Starting at:15.9913.99Bacillus Coagulans Cable Wallplate
Starting at: 13.9915.99 -

Babiesa Cable Wallplate
Starting at:15.9913.99Babiesa Cable Wallplate
Starting at: 13.9915.99 -

Lores Cable Wallplate
Starting at:15.9913.99Lores Cable Wallplate
Starting at: 13.9915.99 -

Winter Cranberry Cable Wallplate
Starting at:15.9913.99Winter Cranberry Cable Wallplate
Starting at: 13.9915.99 -

Sweet Morning Cable Wallplate
Starting at:15.9913.99Sweet Morning Cable Wallplate
Starting at: 13.9915.99 -

Songbird Cable Wallplate
Starting at:15.9913.99Songbird Cable Wallplate
Starting at: 13.9915.99 -

Soda Pop Cable Wallplate
Starting at:15.9913.99Soda Pop Cable Wallplate
Starting at: 13.9915.99 -

Peach Ice Cream Cable Wallplate
Starting at:15.9913.99Peach Ice Cream Cable Wallplate
Starting at: 13.9915.99 -

Old Salt Cable Wallplate
Starting at:15.9913.99Old Salt Cable Wallplate
Starting at: 13.9915.99